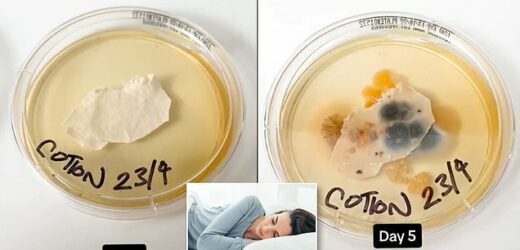

Not washing your pillowcase for just a week causes build-up of 17,000 times more bacteria colonies than a toilet seat, revolting experiment shows
- Lab tests found 3 million bacteria colonies living on dirty pillowcases
- This amount was found on cases that were not washed after one week of use
- READ MORE: How often SHOULD you change your bedding?
If you have not washed your pillowcases in a week, you are likely sleeping on 17,000 more bacteria colonies than what can be found on a toilet seat.
Shocking swab tests of the coverings reveal materials like cotton and silk are teeming with fungus and germs due to your dead skin cells, sweat, feces and saliva.
The experiments collected samples of unwashed pillowcases and let them incubate for up to seven days, revealing bacteria that can cause skin infections and inflammation.
Studies have shown that the average person changes or cleans the cases every 24 days when dermatologists recommend at least twice a week.
Dr Hadley King, a dermatologist and clinical instructor of dermatology at the Weill Medical College of Cornell University, told WellandGood: ‘When you get into bed, you contaminate your bed linens with dead skin cells (about 50 million per day), sweat, makeup, lotions, hair, and anything else you’ve picked up during the day, from pollen and pet dander to fungal mold and dirt particles to bacteria and viral particles as well.
‘Dead skin cells and sweat provide food for dust mites, attracting them to your bed and helping them multiply.’
King continued to explain sleeping on the same pillowcase for one week can cause allergies, skin infections or skin inflammations.
One type of bacteria that can grow on the covers is Staphylococcus aureus, which leads to skin and soft tissue infections such as boils and cellulitis, a condition of the deeper layers of skin and underlying tissue.
AmeriSleep released research this month showing three million bacteria colonies live on a pillowcase that was not in one week.
The mattress company swabbed three volunteers’ unwashed pillowcases at the start of each week for four consecutive weeks to uncover the results.
If you have not washed your pillowcases in a week, you are likely sleeping with 17,000 more bacteria colonies than on a toilet seat
‘After one week, pillowcases contain between three million and five million CFUs (colony-forming units) per square inch,’ AmeriSleep shared in the blog post.
Pillowcases were found to have both bacilli and gram-positive cocci.
Bacilli can cause ocular infections, endocarditis, bacteremia and septicemia, pneumonia, meningitis, and musculoskeletal infections.
And gram-positive cocci can lead to toxic shock syndrome and other infections that can resist antibiotics.
Not only is your pillowcase teeming with bacteria, but it could also be harboring bed buds.
These critters prefer cases over pillow stuffing, so people complaining about bed bugs said they woke up with bite marks on their face, neck, and shoulder area, which turned very itchy and irritated.
Source: Read Full Article